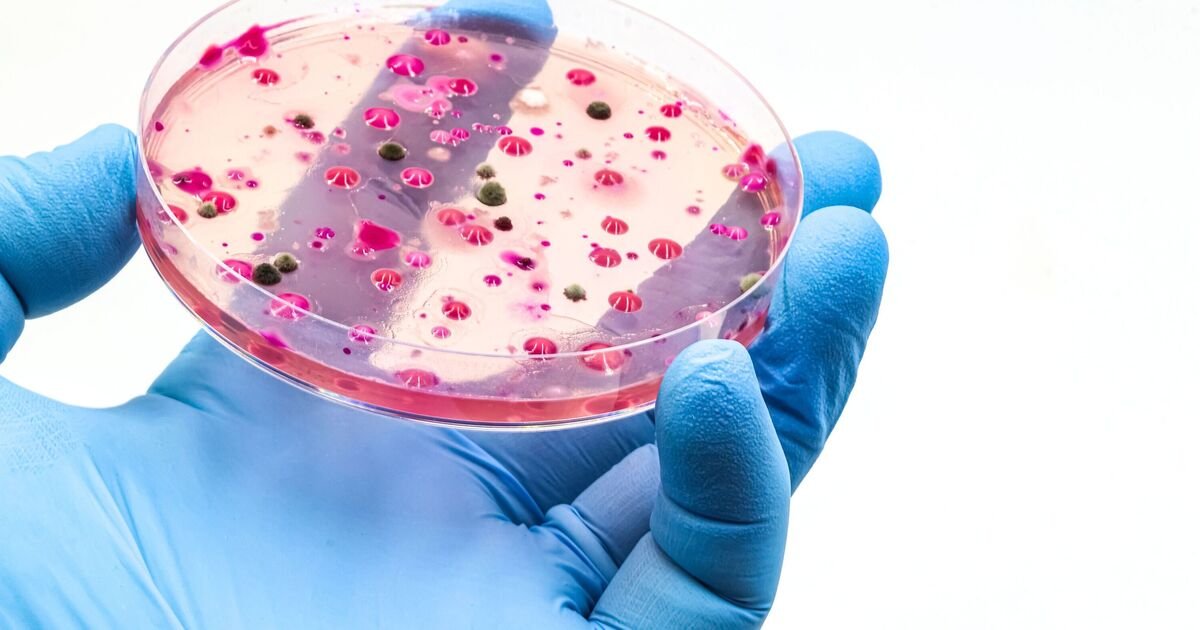
Global Health Alert: Rising Threat of Candida auris Fungus in Hospitals

Global Health Alert: Rising Threat of Candida auris Fungus in Hospitals
### Urgent Warning as Deadly Fungus Spreads Globally
A serious alert has been raised about the spread of a deadly fungus known as Candida auris. Health experts warn that it is becoming more infectious and poses risks to patients worldwide.
C. auris has previously been uncommon in England. However, it has been increasingly detected over the last decade. This rise is particularly noted since travel restrictions linked to the COVID-19 pandemic were lifted, according to the UK Health Security Agency (UKHSA).
The fungus is a significant concern for medical professionals. It can colonise the skin of patients, leading to possible transmission between individuals in hospitals. "Skin colonisation by C. auris is a significant medical concern because colonised patients may facilitate inter- and intra-hospital transmission of C. auris to other patients," the researchers stated.
Additionally, misidentification of the fungus can hinder efforts to control its spread. "Hampered by misidentification," the study highlighted, which adds another layer of complexity in managing this issue.
Efforts are ongoing to address the threat posed by C. auris, as its global impact continues to grow. Public health officials urge healthcare settings to remain vigilant in monitoring and managing infections.
This article is for general information only and is not a substitute for professional medical advice. Always speak to a GP or qualified health professional about your own health.